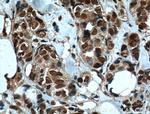
IMP3 Antibody in Immunohistochemistry (Paraffin) (IHC (P))

Search
Proteintech
IMP3 Monoclonal Antibody (1E7D6)
{{$productOrderCtrl.translations['antibody.pdp.commerceCard.promotion.promotions']}}
{{$productOrderCtrl.translations['antibody.pdp.commerceCard.promotion.viewpromo']}}
{{$productOrderCtrl.translations['antibody.pdp.commerceCard.promotion.promocode']}}: {{promo.promoCode}} {{promo.promoTitle}} {{promo.promoDescription}}. {{$productOrderCtrl.translations['antibody.pdp.commerceCard.promotion.learnmore']}}
产品信息
66247-1-IG
种属反应
宿主/亚型
分类
类型
克隆号
抗原
偶联物
形式
浓度
规格
纯化类型
保存液
内含物
保存条件
运输条件
产品详细信息
Immunogen sequence: MVRKLKFHE QKLLKQVDFL NWEVTDHNLH ELRVLRRYRL QRREDYTRYN QLSRAVRELA RRLRDLPERD QFRVRASAAL LDKLYALGLV PTRGSLELCD FVTASSFCRR RLPTVLLKLR MAQHLQAAVA FVEQGHVRVG PDVVTDPAFL VTRSMEDFVT WVDSSKIKRH VLEYNEERDD FDLEA (1-184 aa encoded by BC020557)
靶标信息
This gene encodes the human homolog of the yeast Imp3 protein. The protein localizes to the nucleoli and interacts with the U3 snoRNP complex. The protein contains an S4 domain.
仅用于科研。不用于诊断过程。未经明确授权不得转售。
篇参考文献 (0)
生物信息学
蛋白别名: BRMS2; DKFZp586L0118; FLJ10968; hKOC; IMP3, U3 small nucleolar ribonucleoprotein, homolog; insulin-l; OTTHUMP00000183524; U3 small nucleolar ribonucleoprotein protein IMP3; U3 snoRNP protein 3 homolog; U3 snoRNP protein IMP3; unnamed protein product; VICKZ3
基因别名: 1190002L16Rik; AI256594; BRMS2; C15orf12; IMP3; MRPS4
UniProt ID: (Human) Q9NV31, (Mouse) Q921Y2
Entrez Gene ID: (Human) 55272, (Mouse) 102462